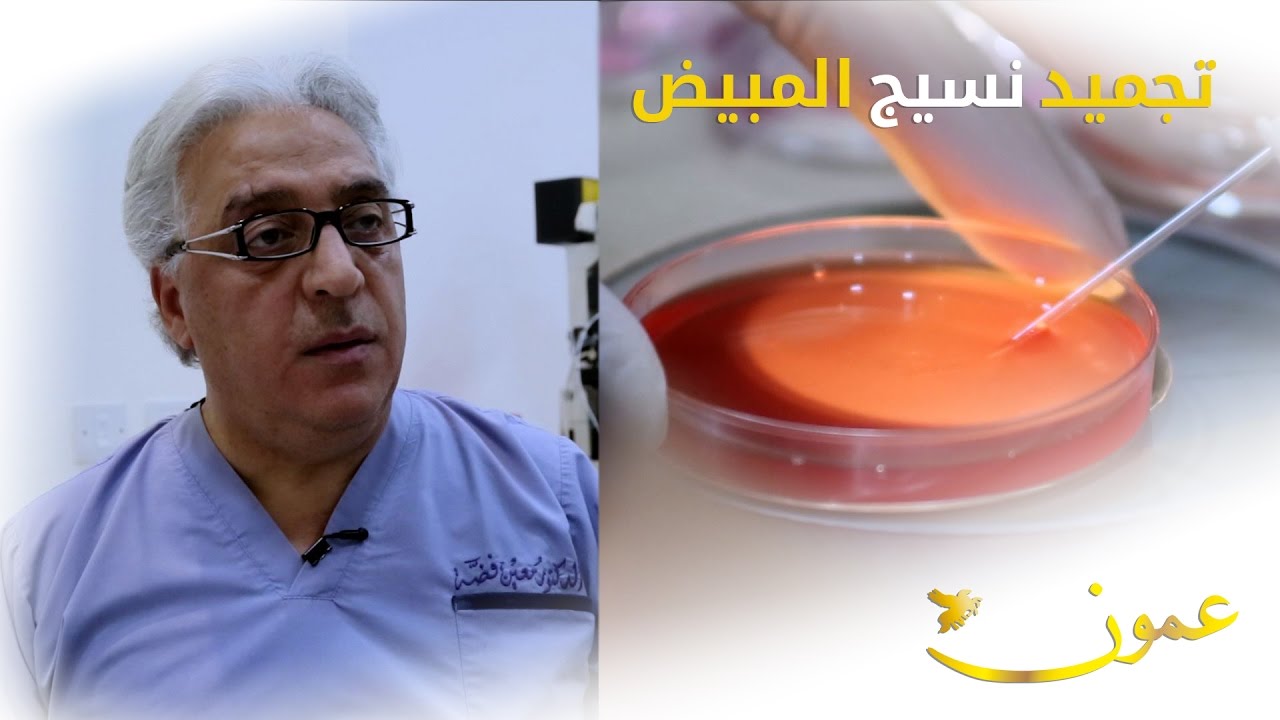
تجميد نسيج المبيض

لأول مرة إمرأة تضع مولودا بعد زرع أنسجة من مبيضها المستأصل
Автор: AlArabiya العربية
Загружено: 2016-12-24
Просмотров: 2686
Описание: لأول مرة إمرأة تضع مولودا بعد زرع أنسجة من مبيضها المستأصل
Повторяем попытку...

Доступные форматы для скачивания:
Скачать видео
-
Информация по загрузке: